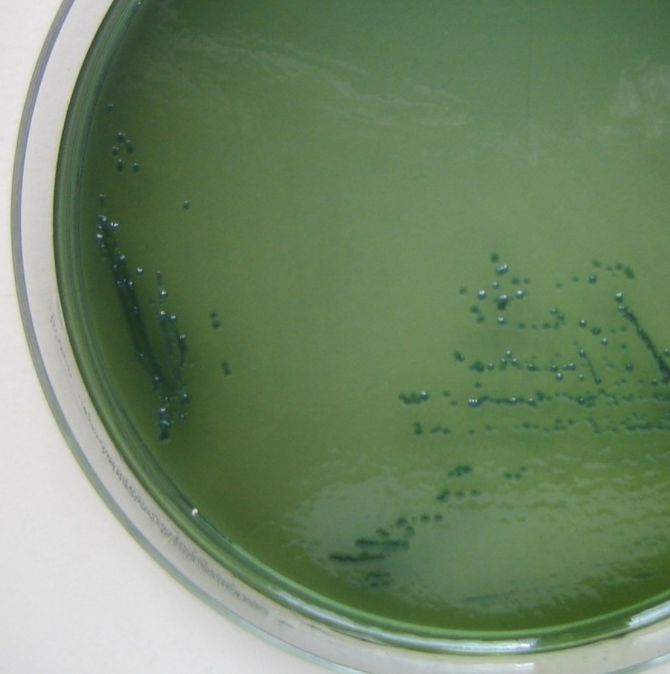
Flashcard 1 image

The image shows the string test/entero test, which is used for the diagnosis of _____

Vibrio _____ produce green colored colonies on TCBS agar
The image given shows a slide with a positive _____ test.

Lowenstein–Jensen is a commonly used, egg-based, selective media which contains _____, which prevents growth of other organisms.

LJ media gives culture result in _____ time
_____ is the IOC for japanese encephalitis
name liquid culture medias for TB
name molecular testing methods for TB
764efae429d34dfaaf5c4ff129c5640b-ao-2

_____ is the gold standard for diagnosing extrapulmonary TB and sputum negative TB
Specimen Collection and Transport
Flashcards
Microscopy in Microbiology
Flashcards
Culture Methods and Media
Flashcards
Bacterial Identification Techniques
Flashcards
Antimicrobial Susceptibility Testing
Flashcards
Serological Diagnosis
Flashcards
Molecular Diagnostic Methods
Flashcards
Rapid Diagnostic Tests
Flashcards
Point-of-Care Testing
Flashcards
Automation in Microbiology Laboratory
Flashcards
Quality Control in Diagnostic Microbiology
Flashcards
Interpretation of Microbiological Reports
Flashcards
Get full access to all flashcards, spaced repetition, and progress tracking.
Start For Free